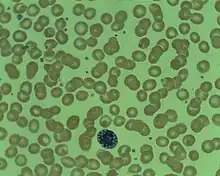

Mott cell
English
smear with a Mott cell at lower center
Etymology
First identified by F. W. Mott.
Noun
Mott cell (plural Mott cells)
- (microbiology) An atypical plasma cell that has spherical inclusions filled with immunoglobulin (small Russell bodies) packed in its cytoplasm.
Synonyms
See also
This article is issued from Wiktionary. The text is licensed under Creative Commons - Attribution - Sharealike. Additional terms may apply for the media files.